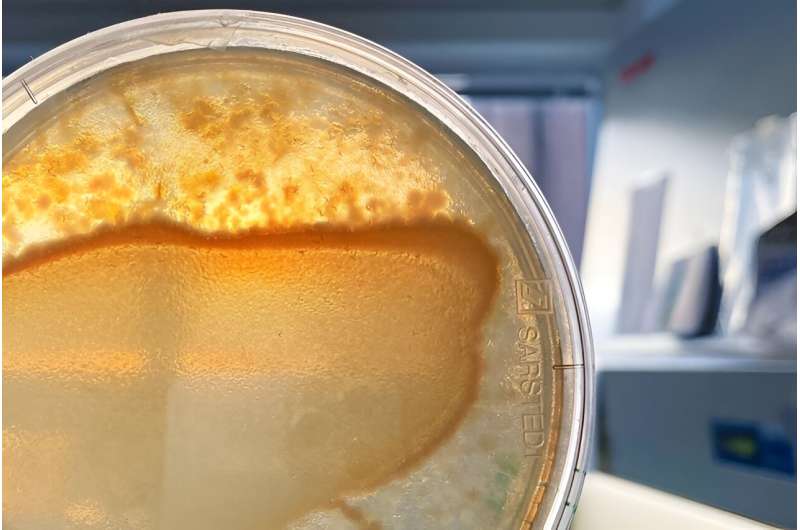
Microbiome Dynamics: Study Reveals Host-Relevant Functions of Bacterial Communities

All multicellular organisms—from the simplest animal and plant organisms to humans—live in close association with a multitude of microorganisms, the so-called microbiome, which colonize their tissues and live in symbiotic relationships with the host.
Many vital functions, such as nutrient uptake, regulation of the immune system, or neurological processes, result from the interactions between the host organism and microbial symbionts. The functional cooperation between host and microorganisms, which scientists refer to as a metaorganism, is being investigated in detail at Kiel University in the Collaborative Research Center (CRC) 1182 Origin and Function of Metaorganisms.
Scientists suspect that the microbiome can significantly contribute to the environmental adaptation and fitness of an organism as a whole. They see one reason for this in the rapid adaptability of microorganisms, which can react many times faster to changing environmental conditions than the usually slower-evolving host organisms.
How the colonization and composition of the microbiome are established during the individual development of the host organism is the subject of current research.
A team from the Evolutionary Ecology and Genetics research group led by Professor Hinrich Schulenburg at the Zoological Institute at Kiel University, together with other research groups from the CRC 1182 from different faculties and the Max Planck Institute for Evolutionary Biology in Plön, has now investigated the dynamics of microbiome colonization.
They found that the microbiome in the nematode's host organism does not have a random composition over a large period of its lifetime, which suggests that the microbial community is the result of directed selection processes. The study is published in mBio.
This assumption is supported by genome analysis of the microbial species in the worm microbiome. Numerous genes were found that are responsible for certain metabolic functions that are important for the host organism and are also relevant in other organisms.
With these results, the Kiel researchers once again show that the roundworm Caenorhabditis elegans is particularly well suited as an informative model organism for researching the gut microbiome.
In order to study the development of microbiome composition in C. elegans over time, Dr. Agnes Piecyk, a former researcher in the Evolutionary Ecology and Genetics group, who planned and led the experiments, used a characteristic community of 43 different bacterial species that are typically found in the nematode in nature.
She introduced this microbial community into previously germ-free animals and colonized them on a culture medium in the direct vicinity of the worms and in separate Petri dishes without any contact with the animals. The researchers then analyzed how the composition of this experimental microbial community changed under various conditions over the course of around a week at six individual points in time—which corresponds to the average lifespan of the threadworms.
In the course of the experiment, it became apparent that time only played a prominent role in the host-associated microbial communities, i.e., the bacteria living in the worms. "Their composition changed in such a way that some specific bacterial species appeared more frequently," says Dr. Johannes Zimmermann, also a researcher in the Evolutionary Ecology and Genetics working group, who analyzed the data.
For example, Ochrobactrum and Enterobacter bacteria accumulate in the worm's gut. "These dynamics cannot be convincingly explained by stochastic, i.e., in principle random, processes. We therefore wanted to find out whether there might be directed processes involved in the dynamic change of the worm microbiome over time," explains Zimmermann.
In the next step, the research team analyzed the genomes of the microorganisms in the worm microbiome containing all the genetic information of the bacterial communities over the worms' lifespan. Interestingly, the researchers found some striking similarities between host-associated microbial communities with genes known from human microbiome research.
"We hypothesize that this is not due to chance but is driven by specific interactions between host and microbiome that affect the microbiome composition at certain points in the host's lifespan.
"A very plausible explanation for the accumulation of certain bacterial species in the worms compared to the control groups could therefore be that the host specifically selects certain bacteria and the functions associated with them, which in turn are advantageous for the host organism," emphasizes Zimmermann.
This hypothesis is further supported by the fact that the favorable microbial functions are universal and go beyond C. elegans, for example, the production of short-chain fatty acids, vitamin B12, or other vital substances.
Overall, the researchers conclude that due to the dynamics of the microbiome composition over the worm's lifetime, the associated bacterial species evolved certain competitive strategies and that, in particular, those species are favored that provide certain useful functions to the host. In conclusion, the colonizing microorganisms, therefore, seem to be beneficial to the host organism overall and thus help it to adapt to its environment.
"With our new work, we provide important conceptual foundations that expand our understanding of the composition and function of the microbiome and how the host organism influences its composition," says Schulenburg.
"Our study based on the experimental microbial community also shows once again that C. elegans provides us with a valuable model system that is also relevant for understanding fundamental processes in the human gut microbiome and their consequences for health and disease," Schulenburg concludes.
More information: Johannes Zimmermann et al, Gut-associated functions are favored during microbiome assembly across a major part of C. elegans life, mBio (2024). DOI: 10.1128/mbio.00012-24
Journal information: mBio
Provided by Kiel University